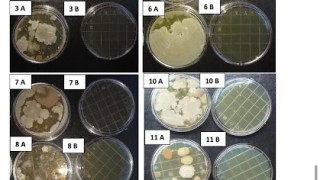
Existosa Prueba

Prueba ferroviaria para el desarrollo de la minería en la PunaSALTA 25 Feb (El Tribuno).-La formación partió desde Buenos Aires y recorrió 2.000 km hasta las estaciones de...

Bajo un contexto gris de la posguerra barcelonesa, en 1943 un grupo de empleados de la sociedad Ferrocarril Metropolitano de Barcelona, S.A. (Transversal) presididos por su...
Trenes de carga, en la vía del crecimientoBUENOS AIRES 20 Jun (Pagina 12).-Trenes Argentinos Cargas (TAC) transportó en lo que va de 2023 2.884.005 toneladas de carga, lo que...
Pese a los precios más bajos, el transporte ferroviario de cargas no creceARGENTINA 28 Mar (El Economista).-Si bien varía según distancia, producto y empresa a cargo, a 2023,...

El Ministerio de Transporte mostrará los avances del Plan de Modernización del TransporteSAN NICOLAS 5 Mar (Expo Agro).-Del 7 al 10 de marzo, el organismo formará parte de La...

Trenes Argentinos Cargas mantiene su crecimiento en toneladas transportadasBUENOS AIRES 15 Sept (Argentina.Gob.ar).-Durante los primeros ochos meses del año, Trenes Argentinos...
El Gobierno de Aragón ha decidido no seguir pagando las líneas regionales deficitarias de la comunidad. La consejería de Vertebración del Territorio gestionada por CHA...

EXITOSA PRUEBA DE LA NUEVA FÓRMULA DE DESINFECCIÓN PARA DISMINUIR EL IMPACTO DEL COVID EN EL TRANSPORTE PÚBLICOBUENOS AIRES 23 Sept(Prensa Ministerio de Transportes).-Con el...

Colocan 14 barreras automáticas para mejorar la seguridad ferroviaria y vialConcluida la obra civil, ya se están instalando en los principales pasos a nivel. Sigue firme el...
Renfe ya anunció a principios de mes que daría marcha atrás a su intención de cerrar el 1 de enero la taquilla de la estación Río Cinca de Monzón, que provocó...

Locomotora de vapor de los Ferrocarriles Andaluces, empresa presidida durante una década por Luis de la Cuadra y Raoul. Fotografía de Trevor Rowe. Archivo Euskotren/Museo...
El fabricante de trenes suizo Stadler fabricará en la planta que tiene en Albuixech (València) un pedido de 60 locomotoras diésel-eléctricas para la finlandesa VR Group, un...
Servicios Ferroviarios de Mallorca, SFM, puso el martes en servicio el tramo electrificado entre la estación de Enllaç y Manacor, con el que no es necesario que los pasajeros...

Locomotora Bitrac en el apartadero de Transportes Vicuña (Alsasua).Estas locomotoras, fabricadas por CAF presentan la posibilidad de circular en líneas electrificadas o sin...

Hacía muchos años que en la estación de Ponferrada la cantidad de vías no era suficiente en relación al movimiento de trenes. Nos comentan que en varias jornadas de estos...
El Ferrocarril de Ponferrada a Villablino

Infografía de algunos TGV y sus récord de velocidad. SNCFEn 1981 daba comienzo la carrera de la muy alta velocidad ferroviaria, el inicio de una dilatada carrera de éxitos...
Viajes ferroviarios de ayer, hoy y mañana